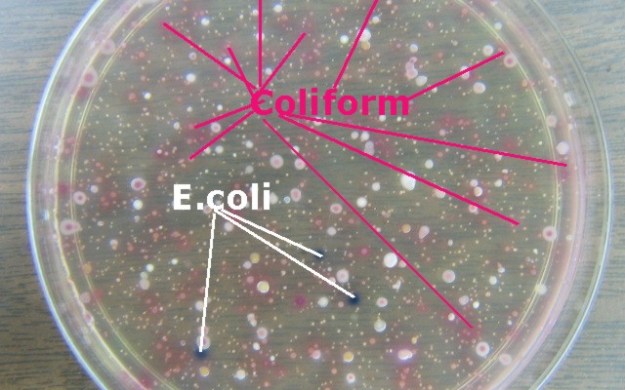

photo source: ecolitestkits.com
written by Nur Akbar Arofatullah/lifepatch.org/Microbiology UGM
Water pollution caused by fecal contamination is a serious problem due to the potential for contracting diseases from pathogens (disease-causing organisms). Frequently, concentrations of pathogens from fecal contamination are small, and the number of different possible pathogens is large. As a result, it is not practical to test for pathogens in every water sample collected. Instead, the presence of pathogens is determined with indirect evidence by testing for an “indicator” organism such as coliform bacteria.
Coliforms come from the same sources as pathogenic organisms. Coliforms are relatively easy to identify, are usually present in larger numbers than more dangerous pathogens, and respond to the environment, wastewater treatment, and water treatment similarly to many pathogens. As a result, testing for coliform bacteria can be a reasonable indication of whether other pathogenic bacteria are present.
The most basic test for bacterial contamination of a water supply is the test for total coliform bacteria. Total coliform counts give a general indication of the sanitary condition of a water supply.
- Total coliforms include bacteria that are found in the soil, in water that has been influenced by surface water, and in human or animal waste.
- Fecal coliforms are the group of the total coliforms that are considered to be present specifically in the gut and feces of warm-blooded animals. Because the origins of fecal coliforms are more specific than the origins of the more general total coliform group of bacteria, fecal coliforms are considered a more accurate indication of animal or human waste than the total coliforms.
Escherichia coli (E. coli) is the major species in the fecal coliform group. Of the five general groups of bacteria that comprise the total coliforms, only E. coli is generally not found growing and reproducing in the environment. Consequently, E. coli is considered to be the species of coliform bacteria that is the best indicator of fecal pollution and the possible presence of pathogens.
At the past river project, we carried out an enumeration of E-Coli bacteria in the water sample colected from the river located in Yogyakarta using traditional spread plate technique on Endo Agar media. Endo agar contains a fuchsin sulfite indicator which makes identification of lactose fermenters relatively easy. Coliform colonies and the surrounding medium appear red on Endo agar. Non-fermenters of lactose, on the other hand, are colorless and does not affect the color of the medium.
This article in lifepatch site : http://lifepatch.org/Investigasi_Pencemaran_Bakteri_Koliform_Sungai_Yogyakarta

Pingback: coliform bacteria detection by PCR | biodesign for the real world